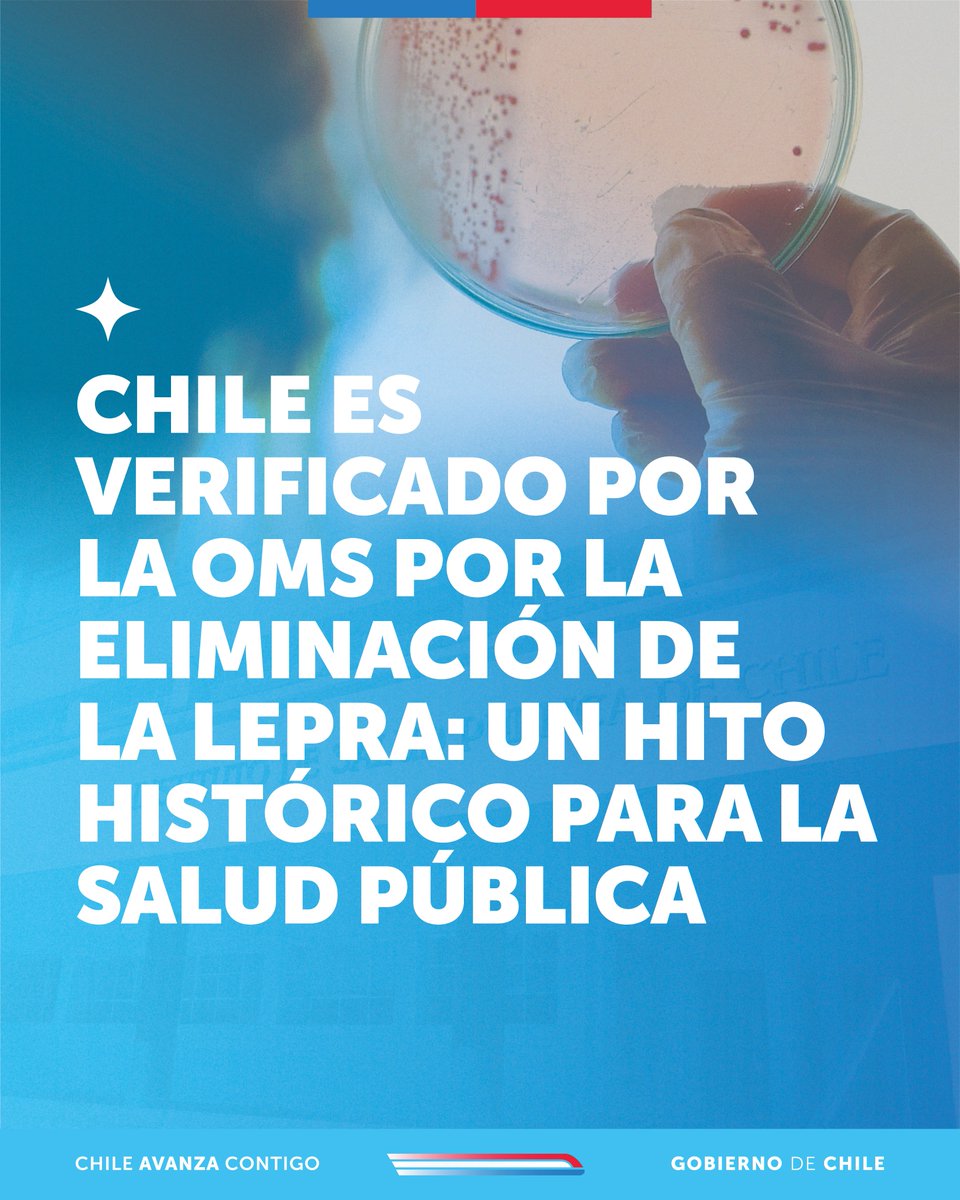
Instituto de Salud Pública de Chile tweet media

Conoce los riesgos de consumir medicamentos fuera de una farmacia al no tener un respaldo que acredite la calidad del producto farmacéutico
Para notificar reacciones adversas ingresa a
👉ispch.cl ⏩Sistemas en Línea ⏩Sistema de Vigilancia Integrada (SVI)

Español